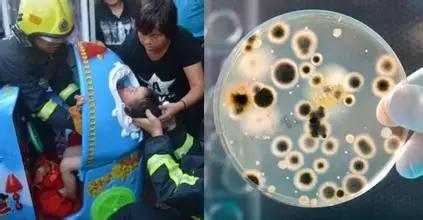
/

无论是大商场还是小商店,随街可见摇摇车,一两块钱就能让小孩子哈哈笑,但是很多家长都不知道,看似可爱的摇摇车会对孩子造成致命伤害!!

摇摇车发生的事故,比比皆是!
张女士3岁的儿子特别爱玩摇摇车,张女士带孩子来商店买吃的,小孩子要坐摇摇车,张女士就投币让自己3岁孩子坐上去玩。
孩子在玩摇摇车,张女士就在旁边看手机。可是没过几分钟张女士听见孩子大叫一声,发现孩子竟然从摇摇车上跌落了下来,面色苍白浑身抽搐,张女士赶紧拨打医院急救电话,孩子被送进了医院。最终3岁的孩子抢救无效,永远地离开了。原来孩子发生事故的原因是在坐摇摇车的过程当中,摇摇车发生漏电,导致孩子触电身亡。
市面上很多摇摇车都是三无产品,坏了都是自己买工具随便修修,即使是合格的摇摇车,因为商家不注意定期维护保养,也会存在很多隐患。
专家分析:其实摇摇车对孩子的危害远不止这些!
损害听力
有人曾现场对对摇摇车进行了噪音测试,结果显示摇摇车音量最高的达102.1分贝,最低也有87.1分贝。一般来说,80分贝以上足以对儿童听力造成危害,如果经常接触,儿童会产生头痛、头昏、耳鸣、记忆力减退等症状。
损害视力
摇摇车的座位前面通常有一个小屏幕,有的能够直接操作玩游戏,有的只是漂亮的装饰画,当摇摇车启动的时候,车身会发生较大幅度的前后摇摆,因为车的晃动,屏幕也不停晃动,而一直盯着屏幕的孩子的眼睛就需要不停地聚焦,很容易造成眼视力疲劳,长此以往将可能引起近视。

卫生状况堪忧
摇摇车大多放在户外,而且没有专人消毒,大部分家长也不会在玩耍前擦拭,而是直接把孩子放在上面,如果刚好处于传染病高发期,那么孩子很容易生病。
危害人身安全
除了上面提到的漏电,需要摇摇车还存在车身破损、驱动装置外露、无安全带等安全隐患。
摇摇车毕竟是小朋友的童年回忆但是孩子的安全问题也是绝不能疏忽的如果孩子喜欢坐摇摇车家长就要做好保护工作啦!1.不足3岁不坐摇摇车虽然摇摇车上的提示是孩子要超过1岁,但是不足3岁的孩子,其身体和心智还是没有发育完善,控制能力也较差,不能做到随机应变。如果出现危险,那么就非常容易受到伤害。所以建议三岁以后再给孩子坐摇摇车,并且家长一定要在旁边监护,不要玩手机、购物等等。2.不坐破损的摇摇车摇摇车都是通过电来驱动,如果表面有破损,那么很可能有意外触电的危险。其次就是一些机械系损伤,比如钥匙孔、裸露的螺丝等等等,这些部位都可能磨损孩子的皮肤。因此在孩子玩耍前,家长最好检查一下摇摇车,看看其是否有破损。①.驱动装置要被包住,孩子就无法接触到铰链等危险零件。②.不准孩子去摸摇摇车的外露驱动装置,以免手指被夹伤或者绞断。③.车身要光滑无破损,避免锐利边缘或锐利尖端伤害孩子。④.车身上不要有间隙或孔洞,以免在运作的过程中夹伤孩子手指。⑤.摇摇车上不能有可拆卸的零件,以免孩子误吞。⑥.最好选择有安全带的摇摇车,避免孩子因为乱动而跌落。
不过小编建议,与其让孩子在摇摇车上担惊受怕,家长不如多跟孩子游戏互动
玩益智玩具,公园郊游。
童年,还是要丰富多彩的~